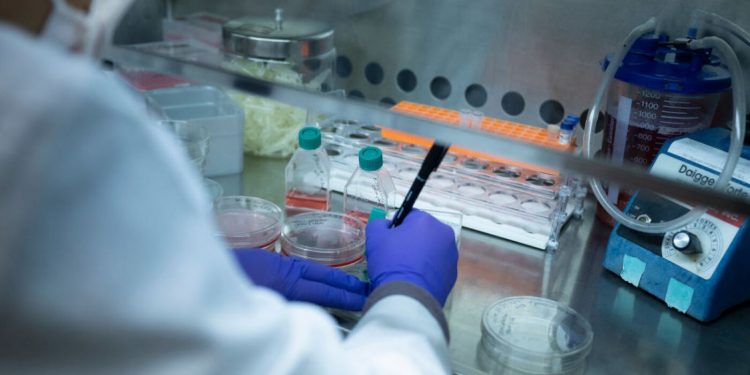
NIH kündigt eine neue Finanzierungsrichtlinie an, die medizinische Forscher klappert: Schüsse

Ein Labor, das Sichelzellenerkrankung im Zell- und Molekular -Therapeutika -Labor des Nationwide Coronary heart, Lung und Blood Institute untersucht, am 8. Februar 2024 in Bethesda, MD, am 8. Februar 2024 in den Nationwide Institutes of Well being.
Brendan Smialowski/AFP über Getty Photos
Bildunterschrift ausblenden
Bildunterschrift umschalten
Brendan Smialowski/AFP über Getty Photos
Die Nationwide Institutes of Well being beschränken eine wichtige Artwork der Finanzierung für medizinische Forschung an Universitäten, medizinischen Fakultäten, Forschungskrankenhäusern und anderen wissenschaftlichen Einrichtungen.
Im Letzter Schritt von der Trump -Administration Beeinflussung der wissenschaftlichen ForschungLaut NIH begrenzt die Agentur die Finanzierung für “indirekte Kosten” auf 15% der Zuschüsse. Das liegt weit unter den vielen Institutionen, die Gebäude und Ausrüstung gewartet und Mitarbeiter und andere Gemeinkosten bezahlt. Zum Beispiel erhält Harvard 68% und Yale erhält laut NIH 67%.
Die NIH sagt, dass die neue Richtlinie, die eine wesentliche Änderung der Förderung der Agenturforschung markiert, eher in den Bereichen non-public Stiftungen entspricht.
“Die meisten privaten Stiftungen, die Fondsforschung im Wesentlichen niedrigere indirekte Kosten liefern als die Bundesregierung, und die Universitäten akzeptieren bereitwillig Zuschüsse aus diesen Stiftungen”, sagt die NIH in einer am Freitag veröffentlichten Mitteilung, in der die Änderung bekannt gegeben wurde.
“Obwohl sich der Zuschussempfänger, insbesondere” neue oder unerfahrene Organisationen “, zu Stipendien für die Deckung indirekter Kosten wie Overhead verwenden … NIH ist verpflichtet, die Auszeichnungen sorgfältig zu steuern, um sicherzustellen Ihre Lebensqualität “, heißt es in der Ankündigung.
Die NIH sagt, dass die Änderung sowohl für aktuelle als auch für zukünftige Zuschüsse gelten wird, und schlägt sogar vor, dass die neue Richtlinie rückwirkend gelten würde. Als Reaktion auf Fragen am Samstag teilte die Abteilung für Gesundheits- und Human Providers, die NIH überwacht, gegenüber NPR mit, dass HHS zwar “die Befugnis habe, diese Änderungen für aktuelle Zuschüsse retrospektiv vorzunehmen und die Stipendiaten zu verpflichten, den zuvor erhaltenen überschüssigen Gemeinkosten zurückzugeben”, während sie den überschüssigen Overhead zurückgeben “, zwar zu verpflichten, diese Änderungen retrospektiv vorzunehmen”, während die Stipendiaten zurückgeben müssen “, zwar die Retrospektive vorzunehmen” Beamte haben “derzeit nicht ausgewählt, um dies nicht zu tun, um die Umsetzung der neuen Fee zu erleichtern”. “Wir werden diese politische Wahl weiterhin bewerten und ob sie im besten Interesse des amerikanischen Steuerzahlers liegt.”
NIH gab 2023 im Geschäftsjahr mehr als 35 Milliarden US -Greenback für quick 50.000 Zuschüsse an mehr als 300.000 Forscher an mehr als 2.500 Universitäten, medizinischen Fakultäten und anderen Forschungsinstitutionen in den USA aus, so die Agentur. Dies beinhaltet 9 Milliarden US -Greenback für indirekte Kosten.
Die neue Politik, die am Montag in Kraft tritt, wird von vielen Forschern verurteilt.
“Dies ist ein todsicherer Weg, um lebensrettende Forschung und Innovation zu verkrüppeln.” Matt OwensPräsident des Charges für Regierungsbeziehungen, eine Vereinigung von Forschungsuniversitäten und akademischen medizinischen Zentren, sagte in einer Erklärung. “Erstattung von Einrichtungen und Verwaltungsausgaben sind Teil der Gesamtkosten für die Durchführung von Weltklasse -Forschung.”
Owens sagt, seine Organisation “prüft diese Richtlinienänderung sorgfältig, da sie dem aktuellen Recht und Richtlinien widerspricht”.
“Amerikas Konkurrenten werden diese selbstverschuldete Wunde genießen”, sagt Owens. “Wir fordern die Führer von NIH auf, diese gefährliche Politik aufzuheben, bevor ihre Schäden von Amerikanern zu spüren sind.”
Diese Gefühle wurden von anderen medizinischen Forschern wiederholt.
“Wir sind alle aufregen”, Dr. George DaleyDer Dekan der Harvard Medical Faculty schrieb NPR in einer E -Mail. “Dies würde die medizinische Forschung dezimieren.”
Die Ankündigung kommt, wie viele Forscher sind schon ängstlich wegen Andere Schritte, die die neue Verwaltung unternommen hateinschließlich Einschränkung der Kommunikation und Reisen durch die NIH und andere Bundesgesundheitsagenturen und das Einfrieren einiger Forschungsstipendien.

Discussion about this post